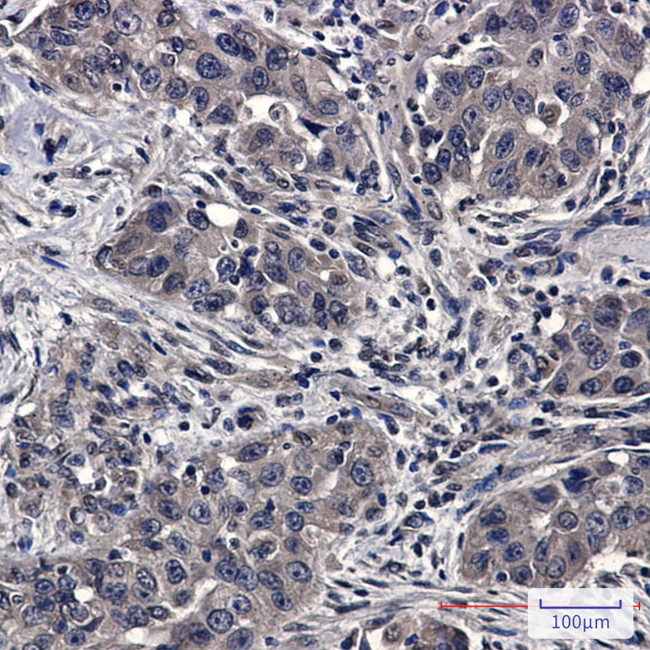
UBE2D1 Antibody in Immunohistochemistry (Paraffin) (IHC (P))

Search
Invitrogen
UBE2D1 Recombinant Rabbit Monoclonal Antibody (K01_2P46)
{{$productOrderCtrl.translations['antibody.pdp.commerceCard.promotion.promotions']}}
{{$productOrderCtrl.translations['antibody.pdp.commerceCard.promotion.viewpromo']}}
{{$productOrderCtrl.translations['antibody.pdp.commerceCard.promotion.promocode']}}: {{promo.promoCode}} {{promo.promoTitle}} {{promo.promoDescription}}. {{$productOrderCtrl.translations['antibody.pdp.commerceCard.promotion.learnmore']}}
图: 1 / 3
UBE2D1 Antibody (MA564207) in IHC (P)



产品信息
MA564207
种属反应
宿主/亚型
Expression System
分类
类型
克隆号
抗原
偶联物
形式
浓度
规格
纯化类型
保存液
内含物
保存条件
运输条件
RRID
产品详细信息
Immunogen sequence: LVPDIAQIYK SDKE
靶标信息
The modification of proteins with ubiquitin is an important cellular mechanism for targeting abnormal or short-lived proteins for degradation. Ubiquitination involves at least three classes of enzymes: ubiquitin-activating enzymes, or E1s, ubiquitin-conjugating enzymes, or E2s, and ubiquitin-protein ligases, or E3s. This gene encodes a member of the E2 ubiquitin-conjugating enzyme family. This enzyme is closely related to a stimulator of iron transport (SFT), and is up-regulated in hereditary hemochromatosis. It also functions in the ubiquitination of the tumor-suppressor protein p53 and the hypoxia-inducible transcription factor HIF1alpha by interacting with the E1 ubiquitin-activating enzyme and the E3 ubiquitin-protein ligases.
仅用于科研。不用于诊断过程。未经明确授权不得转售。
篇参考文献 (0)
生物信息学
蛋白别名: (E3-independent) E2 ubiquitin-conjugating enzyme D1; E2 ubiquitin-conjugating enzyme D1; E2(17)KB 1; SFT; Stimulator of Fe transport; UBC 4/5; UBC4/5 homolog; UBCH 5; UBCH 5A; UbcH5; ubiquitin; Ubiquitin carrier protein D1; ubiquitin conjugating enzyme E2D 1; Ubiquitin-conjugating enzyme E2 D1; Ubiquitin-conjugating enzyme E2(17)KB 1; Ubiquitin-conjugating enzyme E2-17 kDa 1; ubiquitin-conjugating enzyme E2D 1 (UBC4/5 homolog, yeast); ubiquitin-conjugating enzyme E2D 1, UBC4/5 homolog; Ubiquitin-protein ligase D1; unnamed protein product
基因别名: E2(17)KB1; SFT; UBC4/5; UBC5A; UBCH5; UBCH5A; UBE2D1
UniProt ID: (Human) P51668, (Mouse) P61080
Entrez Gene ID: (Human) 7321, (Mouse) 216080